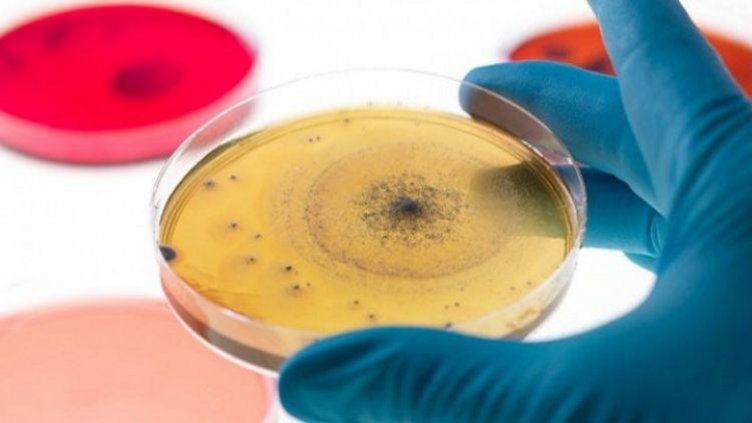
Тръгва най-успешната терапия на хепатит С

Лечението с новия модерен препарат, които лекува хепатит С в 95 до 100% от случаите, ще започне в средата на март. Това стана ясно от изказването на Елена Тотева от НЗОК по време на научна конференция на гастроентеролозите, пише "24 часа". Тя обясни, че приетите от здравната каса критерии за лечение всеки момент ще бъдат публикувани на сайта на осигурителната институция и 15 дни след това лекарството „влиза” в редовна употреба.
Медикаментът беше включен в позитивния лекарствен списък в края на 2015 г. и болните очакват с нетърпение здравната каса да започне да го реимбурсира, защото дава шанс за пълно излекуване. В началото на 2015 г. новите безинтерферонови препарати бяха одобрени за употреба по ускорена процедура първо в САЩ, после и в Европа. Така се действа само за лекарства с огромно значение за общественото здраве.
Лекарството дава ефект още след втората седмица след началото на терапията, показала практиката на водещите хепатолози у нас.
Заболяването се развива бавно, но има изключително лоша прогноза. Хепатит С е вирус, който живее в черния дроб и се предава по кръвен път. В началото липсват симптоми за проблем с черния дроб, затова обикновено той се открива чак в напреднала фаза.
Над 160 милиона души в света са заразени с вируса. В България те са около 110 хиляди, но само 3 на сто от тях се лекуват, като голяма част не се повлияват задоволително от досегашните медикаменти.
Всички пациенти с хепатит С са подходящи за най-новата терапия за това заболяването, но с предимство ще започне лечението на пациентите в най-тежко състояние, обясни проф. Людмила Матева, национален консултант по гастроентерология. Таблетките се приемат от 3 до 6 месеца, като по-продължителният срок е за пациенти в напреднал стадии на чернодробното заболяване. Предимство на новите терапии е, че са подходящи за пациенти с цироза, за болни с генотип 1, за такива, които преминали чернодробна трансплантация, както и за пациенти, които са освен с хепатит C са инфектирани и с ХИВ и за лекувани с опиоидна субстанция.
Гастроентеролозите обсъдиха и случаи на обратно развитие на цироза в резултат на лечението.
На въпрос на „24 часа” дали средствата, предвиждани за лечение на пациенти с хепатит С ще са достатъчни за достъпна на всички пациенти, гастроентерологът д-р Радин Цонев отговори, че лекарят се ръководи в избора на терапия от медицинските критерии. Да не назначиш на пациент лечението, от което се нуждае, означава да го дискриминираш, коментира той.

Патриарх Даниил почете паметта на патриарх Максим
Патриарх Даниил почете паметта на патриарх Максим  Тръмп наложил незаконно глобалните търговски мита?
Тръмп наложил незаконно глобалните търговски мита?  Разбиха престъпна група за трафик на нелегални мигранти (ВИДЕО)
Разбиха престъпна група за трафик на нелегални мигранти (ВИДЕО)  България има потенциал да се превърне в медицинска дестинация на световно ниво
България има потенциал да се превърне в медицинска дестинация на световно ниво 
 На Земята започнаха силни магнитни бури
На Земята започнаха силни магнитни бури  Две мощни светкавици удариха повърхността на Луната
Две мощни светкавици удариха повърхността на Луната  Гигантска ударна вълна се разпространява през Млечния път
Гигантска ударна вълна се разпространява през Млечния път  Опасна ли е за Земята черната дупка Gaia BH1
Опасна ли е за Земята черната дупка Gaia BH1 
 Нейтън Бендон влиза в битка за респект и слава на SENSHI 29
Нейтън Бендон влиза в битка за респект и слава на SENSHI 29  Левски трепери: ЦСКА се намира в най-добрата си форма
Левски трепери: ЦСКА се намира в най-добрата си форма  Фондация „Григор Димитров“ стартира национална програма „Образование за здраве“
Фондация „Григор Димитров“ стартира национална програма „Образование за здраве“  Ламин Ямал разкри бъдещето си в Барса
Ламин Ямал разкри бъдещето си в Барса 
 Задължителни ястия за Архангеловден
Задължителни ястия за Архангеловден  От хип-хоп клубовете в Харлем до подиумите на Висшата мода – историята на streetwear стила
От хип-хоп клубовете в Харлем до подиумите на Висшата мода – историята на streetwear стила  Гледайте Made in EU с участието на Герасим Георгиев – Геро и Иван Бърнев от 21 ноември в кината
Гледайте Made in EU с участието на Герасим Георгиев – Геро и Иван Бърнев от 21 ноември в кината  Изберете магическо кълбо и вижте какво ви очаква
Изберете магическо кълбо и вижте какво ви очаква 
 Стотици гени действат различно в мозъка на жената и на мъжа
Стотици гени действат различно в мозъка на жената и на мъжа  Когнитивно-комуникативни нарушения: Скритите предизвикателства след травма на мозъка
Когнитивно-комуникативни нарушения: Скритите предизвикателства след травма на мозъка  Как да се справим със запека по време на бременност?
Как да се справим със запека по време на бременност?  Уреаплазмена инфекция – една от причините за безплодие
Уреаплазмена инфекция – една от причините за безплодие 
 дава под наем, Склад, 110 m2 София, Левски, 664.68 EUR
дава под наем, Склад, 110 m2 София, Левски, 664.68 EUR  дава под наем, Двустаен апартамент, 73 m2 София, Витоша, 550 EUR
дава под наем, Двустаен апартамент, 73 m2 София, Витоша, 550 EUR  дава под наем, Къща, 182 m2 София, Малинова Долина, 2700 EUR
дава под наем, Къща, 182 m2 София, Малинова Долина, 2700 EUR  дава под наем, Четиристаен апартамент, 170 m2 София, Малинова Долина, 1850 EUR
дава под наем, Четиристаен апартамент, 170 m2 София, Малинова Долина, 1850 EUR 










 Норвежката централна банка запази лихвите без промяна и не очаква скорошно намаление
Норвежката централна банка запази лихвите без промяна и не очаква скорошно намаление  Иновации без граници: Науката среща бизнеса в България
Иновации без граници: Науката среща бизнеса в България  Лидери пропускат COP30, докато целта за 1,5°C става все по-недостижима
Лидери пропускат COP30, докато целта за 1,5°C става все по-недостижима  Най-скъпата магистрала в Европа ще бъде безплатна
Най-скъпата магистрала в Европа ще бъде безплатна  България има потенциал да се превърне в медицинска дестинация на световно ниво
България има потенциал да се превърне в медицинска дестинация на световно ниво  Джим Къртис се обясни в любов на Дженифър Анистън
Джим Къртис се обясни в любов на Дженифър Анистън
Коментари